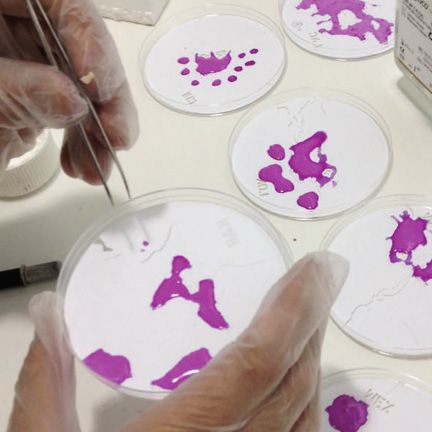

Can the rate in which the human population grows be seen as a sustainable factor for our environment ? It’s estimated that the human population would reach near 11 billion people within the next 100 years.
Terreform an architectural organization which practice combines both urban and environmental issues, proposed The Bio City World Map which utilizes the shape of Buckminster Fuller Dymaxion Map and predicts the outcome of the world’s population within 100 years. The map merges world cities into one unified population growth allowing the changes in density to be viewed over time as one construct.
 Terreform argues that majority of developing nations cannot understand population growth by just analyzing one particular city so in order to acknowledge it in full depth, long-term effects of population density from the present and the future should be viewed in relation to one another.
Terreform argues that majority of developing nations cannot understand population growth by just analyzing one particular city so in order to acknowledge it in full depth, long-term effects of population density from the present and the future should be viewed in relation to one another.
 The map’s back side takes a closer look into each individual cities as if they were grown inside a petri dishes. Terreform was able to combine biological analysis with technical application to emphasis and illustrate the changes in our environment in a close up scale.
The map’s back side takes a closer look into each individual cities as if they were grown inside a petri dishes. Terreform was able to combine biological analysis with technical application to emphasis and illustrate the changes in our environment in a close up scale.
“ Our method creates a real-time parametric display using Gammaproteo Bacterium Escherichia coli Strain K12 in agar medium that has been genetically modified to express color under UV light. The strains used are harmless variants of E. coli, commonly studied all across Europe and the United States. They have been utilized in schools for decades without any safety issues and are considered non-pathogenic and innocuous.”
 Terreform aims to prove that technological computation and biological representation can in fact lead to a better understand of the future changes within our environment.
Terreform aims to prove that technological computation and biological representation can in fact lead to a better understand of the future changes within our environment.